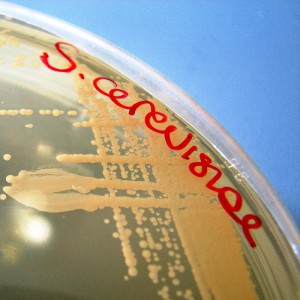

I seem to be overdue for a station identification. And, all the more urgent, as I was recently mentioned in an article in the NYT (why, oh, why do I always miss these traffic spikes?).
I seem to be overdue for a station identification. And, all the more urgent, as I was recently mentioned in an article in the NYT (why, oh, why do I always miss these traffic spikes?).
So, hello, all of you who still stick around here to read my ramblings. And, hello, to all of you who wonder who the heck Charlie Schick is and how did he manage to get his name in the NYT?
Practical microbiology (and then some)
My name is Charlie Schick. I am Director of Marketing, for Big Data and Warehousing products at IBM. My focus is Healthcare and Life Sciences (I have a PhD, by the way). I thoroughly enjoy this job, as it allows me to talk science and healthcare, while working for an amazing tech leader.
Prior to that I was at Children’s Hospital Boston (as fundraiser and as scientist and faculty – though roles separated by a decade), and Nokia (total hack in marketing and product management). If you’re interested in knowing more of my tenure at those two places, feel free to invite me to lunch or beer.
Thinking rather than doing
Throughout my life, I have dabbled in many things – building things from bio-molecules to web publications to communities. I am always happy to get deep into the tech (bio or otherwise) and get my hands dirty and tinker. In the past few years, I’ve returned to my first love – biology – and have been studying the practical uses of microbiology, such as probiotics, functional foods, physiology, and the like (just see the things I’ve been posting and commenting on here on this site and on Twitter).
Alas, I have a wide range of interests (see my About page) and I have a very active family, so I’m more of a thinker than a doer. I suppose one day I’ll find the right doer for my thinking and we’ll have a blast. Until then, I’ll keep writing (I managed to complete NaNoWriMo last year) and fermenting foods.
As I said before, if you want to learn more, I’m in the Boston area and always welcome a free beer.
Where does DIYbio come in?
I’m more of a lurker and booster. That’s all. Attended a few meetings, really haven’t used the wetspace yet (it’s 30 miles from home). But I provide input where I can and let everyone know all the great stuff going on. For example, Happy Birthday Genspace!
DIYbio also gives me an excuse to talk bio with enthusiasts. How great is that?
Do you DIYbio? Have you ever DIYbio?
And of course, my standard disclaimer (riffing off of Cringley)
Everything I write here on this site is an expression of my own opinions, NOT of my employer, IBM. If these were the opinions of IBM, the site would be called ‘IBM something’ and, for sure, the writing and design would be much more professional. Likewise, I am an intensely trained professional writer :-P, so don’t expect to find any confidential secret corporate mumbo-jumbo being revealed here. Everything I write here is public info or readily found via any decent search engine or easily deduced by someone who has an understanding of the industry.
On the flip side, this is my personal site. Please don’t flood me with ideas that you think IBM might be interested in. There are other channels for such biz dev, and this site is not part of them.
Image from Rising Damp